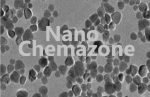
Nano Magnesium Hydroxide

Magnesium Hydroxide Nanoparticles
$0.00
Magnesium Hydroxide Nanoparticles
Nano Magnesium Hydroxide
Magnesium Hydroxide Nanopowders
| MF: | Mg(OH)2 |
| Chemical Name: | Magnesium Hydroxide |
| Purity: | > 99.99% |
| APS: | 80 nm (Size Customization possible) |
| Form: | Nanopowder |
| Product Number: | #NCZ4001 |
| CAS Number | 1309-42-8 |
Note: We supply different products of microparticles and Nanoparticles powder in all size range according to client’s requirements.
Category: Nanoparticles & Nanopowders
Description
Note: For pricing & ordering information, please contact us at sales@nanochemazone.com
Please contact us for quotes on Larger Quantities & Customization. E-mail: contact@nanochemazone.com
Customization:
If you are planning to order large quantities for your industrial and academic needs, please note that customization of parameters (such as size, length, purity, functionalities, etc.) are available upon request.
Shipping & Delivery
Related products
Aluminum Nitride Nanoparticles
$0.00
Aluminum Nitride Nanoparticles
| MF: | AlN |
| Chemical Name: | Aluminum Nitride |
| Purity: | > 99.99% |
| APS: | ≤100 nm (Size Customization possible) |
| Form: | Nanopowder |
| Product Number: | #NCZ401 |
| CAS Number | 24304-00-5 |
Carbon Nanopowder
$0.00
Carbon Nanopowder
Activated Carbon Nanoparticles
Nano Activated carbon powder
| MF: | C |
| Chemical Name: | Carbon |
| Purity: | > 99.99% |
| APS: | 20 nm (Size Customization possible) |
| Form: | Nanopowder |
| Product Number: | #NCZ1301 |
| CAS Number | 7440-44-0 |
Cobalt Ferrite Nanoparticles
$0.00
Cobalt Iron Oxide Nanopowder
Cobalt Ferrite Nanoparticles
Nano Cobalt Iron Oxide/Cobalt Ferrite powder
| MF: | CoFe2O4 |
| Chemical Name: | Cobalt Iron Oxide/Cobalt Ferrite Nanoparticles |
| Purity: | > 99.99% |
| APS: | 30 nm (Size Customization possible) |
| Form: | Nanopowder |
| Product Number: | #NCZ1901 |
| CAS Number | 12052-28-7 |
Cobalt Nanoparticles
$0.00
Cobalt Nanopowder
Cobalt Metal Nanoparticles
Cobalt Nanoparticles
Nano Cobalt Nanopowder
| MF: | Co |
| Chemical Name: | Cobalt |
| Purity: | > 99.99% |
| APS: | 20 nm (Size Customization possible) |
| Form: | Nanopowder |
| Product Number: | #NCZ1801 |
| CAS Number | 7440-48-4 |
Diamond Nanoparticles
$0.00
Nano Diamond Powder
Diamond nanoparticles
Carbon Diamond powder
| MF | C |
| Chemical Name | Carbon Diamond, Nano-Diamond |
| Purity | > 99% |
| APS | 6 nm (Size Customization possible) |
| Form | Nanopowder |
| Product Number | #NCZ2401 |
| CAS Number | 7782-40-3 |
Dysprosium Oxide Nanoparticles
$0.00
Dysprosium Oxide Nanoparticles
Dysprosium Oxide Nanopowder
Nano Dysprosium Oxide
| MF: | Dy2O3 |
| Chemical Name: | Dysprosium Oxide |
| Purity: | > 99.99% |
| APS: | 20 nm (Size Customization possible) |
| Form: | Nanopowder |
| Product Number: | #NCZ2501 |
| CAS Number | 1308-87-8 |
Erbium Oxide Nanoparticles
$0.00
Erbium Oxide nanoparticles
Erbium Oxide nanopowder
Nano Erbium Oxide powder
| MF: | Er2O3 |
| Chemical Name: | Erbium Oxide |
| Purity: | > 99.99% |
| APS: | 20 nm (Size Customization possible) |
| Form: | Nanopowder |
| Product Number: | #NCZ2601 |
| CAS Number | 12061-16-4 |
Graphene Nanoplatelets
$0.00
Graphene Nanoplatelets
| MF: | C |
| Chemical Name: |
Graphene Nanoplatelets |
| Purity: | > 99.99% |
| APS: | 5-10 µm, 20-50 layers (Size Customization possible) |
| Form: | Nanopowder |
| Product Number: | #NCZ3001 |
| CAS Number | 99685-96-8 |